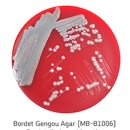
H1883 이미지

H1883 총69명이 열람하였으며, 0개의 리뷰가 있습니다.
- 무인교통단속카메라관리번호
- H1883
- 시도명
- 경상북도
- 시군구명
- 김천시
- 도로종류
- 고속국도
- 도로노선번호
- 45호
- 도로노선명
- 중부내륙고속도로
- 도로노선방향
- 2
- 소재지지번주소
- 경상북도 김천시 아포읍 송천리 산 119-2
- 설치장소
- 중부내륙고속도로 113.2k 시점 1,2차로(김천시 아포읍 송천리)(성주 방면)
- 단속구분
- 99
- 제한속도
- 100
- 단속구간위치구분
- 1
- 과속단속구간길이
- 9
- 보호구역구분
- 99
- 설치연도
- 2,021
- 관리기관명
- 경상북도경찰청
- 관리기관전화번호
- 054-824-2152
- 데이터기준일자
- 2024-09-09
- 제공기관코드
- 1,320,000
- 제공기관명
- 경찰청
주변 목록 (8)
H1882
'H1883'에서 0.1km
054-824-2152
바로가기
G7880
'H1883'에서 0.8km
054-824-2152
바로가기
J0266
'H1883'에서 0.9km
054-824-2152
바로가기
G3725
'H1883'에서 1km
054-824-2152
바로가기
gc-camera-024
'H1883'에서 1km
054-420-6661
바로가기
H5025
'H1883'에서 1.4km
054-824-2152
바로가기
H5026
'H1883'에서 1.4km
054-824-2152
바로가기
gc-camera-033
'H1883'에서 2.4km
054-420-6661
바로가기
주변 대중 교통 환승 센터 (12)
동대구역 복합환승센터
대구광역시 동구 동부로 149
'H1883'에서 44.16km
바로가기
㈜의령버스터미널
경상남도 의령군 의령읍 의병로6길 13
'H1883'에서 92.16km
바로가기
세종시복합환승센터
세종특별자치시 갈매로 37-12
'H1883'에서 96.16km
바로가기
오송역 버스환승센터
충청북도 청주시 흥덕구 오송읍 오송가락로123
'H1883'에서 99.4km
바로가기
양산역 환승센터
경상남도 양산시 강변로 438(중부동)
'H1883'에서 113.1km
바로가기
익산역환승장
전북특별자치도 익산시 익산대로 153
'H1883'에서 121.19km
바로가기
배방환승정류장
'H1883'에서 128.41km
바로가기
영인환승정류장
충청남도 아산시 송악면 외암로 1030-14
'H1883'에서 129.5km
바로가기
모종환승정류장
충청남도 아산시 번영로 223
'H1883'에서 132.66km
바로가기
송악환승정류장
'H1883'에서 141.46km
바로가기
오산역환승센터
경기도 오산시 역광장로 59
'H1883'에서 154.32km
바로가기
광교중앙(아주대)역 버스환승센터
경기도 수원시 영통구 도청로 지하 45
'H1883'에서 166.86km
바로가기
주변 교통 사고 다발지역 (12)
2020015
경상북도 구미시1
'H1883'에서 5.52km
바로가기
2022083
경상북도 칠곡군2
'H1883'에서 21.7km
바로가기
2019038
대구광역시 북구6
'H1883'에서 40.28km
바로가기
2015046
대구광역시 달서구13
'H1883'에서 42.47km
바로가기
2021017
대구광역시 달서구1
'H1883'에서 43.22km
바로가기
2014095
경상북도 경산시1
'H1883'에서 55.68km
바로가기
2019066
대전 대전둔산1
'H1883'에서 83.32km
바로가기
2018028
경상남도 함양군1
'H1883'에서 85.37km
바로가기
2016040
충청북도 청주시 서원구1
'H1883'에서 86.42km
바로가기
2018027
충청북도 청주시 서원구1
'H1883'에서 86.86km
바로가기
2021030
충북 청주흥덕1
'H1883'에서 91.76km
바로가기
2017081
울산 울산중부1
'H1883'에서 115.67km
바로가기
주변 신호등 (12)
경상북도 구미시 야은로 713
'H1883'에서 8.25km
바로가기
UR-[안말로]-상-3
'H1883'에서 205.37km
바로가기
UR-[안말로]-상-1
'H1883'에서 205.4km
바로가기
UR-[전좌로]-상-39
'H1883'에서 205.48km
바로가기
UR-[회룡로]-하-9
'H1883'에서 205.94km
바로가기
UR-[신흥로]-상-50
경기도 의정부시 신흥로 58
'H1883'에서 206.01km
바로가기
UR-[장곡로]-상-28
'H1883'에서 206.03km
바로가기
UR-[신흥로]-상-52
'H1883'에서 206.04km
바로가기
UR-[회룡로]-상-8
'H1883'에서 206.49km
바로가기
UR-[회룡로]-상-7
'H1883'에서 206.49km
바로가기
UR-[신흥로]-상-34
'H1883'에서 206.5km
바로가기
UR-[신흥로]-상-36
'H1883'에서 206.55km
바로가기
주변 횡단보도 (12)
송선로1길-1
경상북도 구미시 송선로1길 41-1
'H1883'에서 1.71km
바로가기
송선로2길-1
경상북도 구미시 송선로1길 41-1
'H1883'에서 1.71km
바로가기
송선로4길-2
경상북도 구미시 송선로1길 41-1
'H1883'에서 1.72km
바로가기
송선로3길-1
경상북도 구미시 송선로1길 41-1
'H1883'에서 1.74km
바로가기
송선로-2
경상북도 구미시 송선로 209-1
'H1883'에서 2.13km
바로가기
야은로-14
경상북도 구미시 야은로 106
'H1883'에서 2.22km
바로가기
야은로-15
경상북도 구미시 야은로 106
'H1883'에서 2.22km
바로가기
야은로-16
경상북도 구미시 야은로 106
'H1883'에서 2.23km
바로가기
송선로4길-1
경상북도 구미시 송선로4길 7
'H1883'에서 2.29km
바로가기
야은로5길-1
경상북도 구미시 야은로5길 3
'H1883'에서 2.89km
바로가기
봉곡북로-1
경상북도 구미시 봉곡북로 9
'H1883'에서 3.13km
바로가기
야은로-13
경상북도 구미시 야은로 191
'H1883'에서 3.2km
바로가기
주변 휴게소 (12)
김천(부산)
고속국도
'H1883'에서 9.76km
바로가기
김천(서울)
고속국도
'H1883'에서 9.78km
바로가기
선산(창원)
고속국도
'H1883'에서 14.02km
바로가기
선산(양평)
고속국도
'H1883'에서 14.45km
바로가기
성주(창원)
고속국도
'H1883'에서 15.44km
바로가기
성주(양평)
고속국도
'H1883'에서 15.69km
바로가기
칠곡(부산)
고속국도
'H1883'에서 20.21km
바로가기
칠곡(서울)
고속국도
'H1883'에서 20.97km
바로가기
추풍령(서울)
고속국도
'H1883'에서 24.65km
바로가기
추풍령(부산)
고속국도
'H1883'에서 24.92km
바로가기
동명(부산)
고속국도
'H1883'에서 29.41km
바로가기
동명(춘천)
고속국도
'H1883'에서 29.66km
바로가기
블로그 리뷰
-
x H1883 x D294mm 벽걸이 제품크기 : W820 x H299 x D215mm 제조년월 : 2022.04 리모컨, 실외기 포함 상품 에어컨 설치는 개별적으로 따로 받으셔야 합니다. 배송시 유의사항 제품 고장이 아닌 단순변심이나, 사이즈 미확인으로 (엘레베이터, 현관입구 사이즈 등) 배송 설치 어려울시 왕복배송료 부담해주셔야 합니다...
충주 중고가전 매입/판매 전문업체 (동촌리싸이클홈)(2026-05-21 08:00:00)

일별 방문 통계
월별 방문 통계
카카오맵 바로가기
카카오맵 위치 기준 길안내
리뷰 (0)
등록된 리뷰가 없습니다.
관련 지도 선택 및 번역
첨부파일